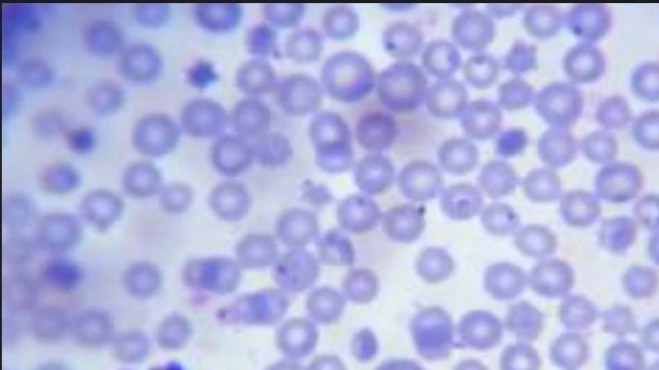
Special Stain: Giemsa Stain

تفاصيل التحليل
صبغة جيمزا النسيجية (Giemsa Stain)
صبغة كلاسيكية متعددة الاستخدامات للكشف عن الطفيليات مثل الملاريا وبعض أنواع البكتيريا، توفر تفاصيل دقيقة لخلايا الدم لتشخيص الأمراض المعدية والدموية بكفاءة.
الصورة التوضيحية المرتبطة بهذا التحليل